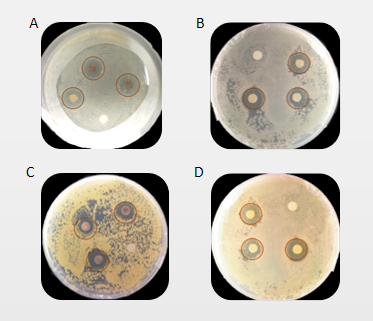

基于槐糖脂绿色合成纳米银抗菌材料毕业论文
2020-04-26 12:56:23
摘 要
槐糖脂(SL)是目前已知的微生物表面活性剂中研究与应用最为普遍的一种。研究表明,他可以应用于纳米技术中,合成并结合纳米金属离子。槐糖脂封端的Ag纳米颗粒是高效的抗菌剂,对抗两者革兰氏阳性和革兰氏阴性细菌都有良好的抗菌性。在重视环境友好型生产的今天,这一类生物表面活性剂会有很好的应用前景,并且作为新一代的多功能材料将受到越来越多的重视。
本文主要阐述了槐糖脂的相关应用以及用槐糖脂结合的银纳米粒子的合成方法及作用。设计创新的方法来合成具有新颖功能的核壳型结构材料,在绿色合成途径和使用天然生物质合成生物纳米材料相关研究的基础上,利用槐糖脂作为还原剂和封端剂进行一步法制备纳米银颗粒。在制备过程中,还探究了反应时间、反应温度,槐糖脂添加浓度以及反应体系的pH对纳米银颗粒形成的影响。在确定最佳反应条件之后,再将所得的纳米银颗粒(SL-Nps)进行抗菌实验,探究其抗菌效果。其中包括对大肠杆菌(E.coli)、铜绿假单胞菌(P.aeruginosa)、金黄色葡萄球菌(S.aureus)、热带假丝酵母(C.andida)四种菌类的抗菌效果。
通过实验结果表明以槐糖脂为基础的纳米银结构可以在加热条件下通过一步法制备。其最佳制备条件见后文。并且制备的纳米银具备广谱杀菌作用,对革兰氏阳性菌(G )和革兰氏阴性菌(G-)均有较好的抗菌效果。在抗菌实验中,其对E.coli 、P.aeruginosa、S.aureus的最小杀菌浓度(MBC)分别为1 g·L-1、0.5 g·L-1、0.5 g·L-1、4 g·L-1,极少的纳米银即可产生强大的杀菌作用。可以预期,纳米银在直接接触人体、对作用安全性有较高要求以及目前应用纳米银作为抗菌成分的抗菌产品中会有很好的应用前景。同时,槐糖脂一步合成功能性微纳米材料方法的简易性,使其可用于其他金属或合金(如Au)微纳米结构的研究。
关键词:槐糖脂 一步合成 纳米银 抗菌
Abstract
Sophorolipid(SL) is one of the most commonly studied and applied microbial surfactants. Studies have shown that he can be applied to nanotechnology to synthesize and combine nanometal ions. Glycolipid-terminated Ag nanoparticles are highly effective antibacterial agents that have good antibacterial properties against both Gram-positive and Gram-negative bacteria. Today, with the emphasis on environmentally friendly production, this type of biosurfactant has a good application prospect and will receive more and more attention as a new generation of multifunctional materials.
This paper mainly describes the related applications of sophorolipids and the synthesis methods and functions of silver nanoparticles combined with sophorolipids. Designing innovative methods to synthesize core-shell structural materials with novel functions. Based on the research of green synthesis pathways and the use of natural biomass to synthesize bio-nanomaterials, one-step preparation was carried out using sophorolipids as reducing agents and blocking agents. Nano silver particles. In the preparation process, the reaction time, the reaction temperature, the concentration of sophorolipid addition and the effect of pH of the reaction system on the formation of nano-silver particles were also investigated. After determining the optimal reaction conditions, the obtained nano silver particles (SL-Nps) were subjected to an antibacterial experiment to investigate the antibacterial effect. These include antibacterial effects against E. coli, P. aeruginosa, S. aureus, and C. andida.
The experimental results show that the nano-silver structure based on sophorolipid can be prepared by one-step method under heating conditions. The optimum preparation conditions are described later. The prepared nano silver has a broad-spectrum bactericidal effect and has good antibacterial effects against Gram-positive bacteria (G ) and Gram-negative bacteria (G-). In the antibacterial experiment, the minimum bactericidal concentration (MBC) for E. coli, P. aeruginosa, S. aureus is 1 g·L-1, 0.5 g·L-1, 0.5 g·L-1, 4 g · L-1, respectively. , very little nano silver can produce a strong bactericidal effect. It can be expected that nano silver will have a good application prospect in the direct contact with the human body, high requirements on the safety of action, and the current application of nano silver as an antibacterial component. At the same time, the simplicity of the method of synthesizing functional micro-nanomaterials in one step makes it useful for the study of micro-nanostructures of other metals or alloys (such as Au).
Key Words: Sophorolipid; one-step synthesis; Silver nanoparticle; Antibacteria
目 录
摘要。。。。。。。。。。。。。。。。。。。。。。。。。。。。。。。。。。。。。。。。。。。。。。。。。。。。。。。。。。。。。。。。。。。。。。。。。。。。。。。。。。。。。。。。。。。。。。。。。。。。。。。。。。。。。。。。。。。。。。。。。。。。。。。。。。。。。。。。。。。。。。。。。。。。。。。。。。I
第一章 引言 1
第二章 文献综述 2
2.1 制备纳米银颗粒的概述 2
2.1.1 常规制备纳米银方法 2
2.1.2生物材料合成纳米银颗粒 2
2.2 槐糖脂概述 4
2.2.1 槐糖脂及其性质 4
2.2.2槐糖脂的应用 5
2.3 银颗粒的不同类型与相关性质 6
2.3.1 纳米银 6
2.3.2 纳米银 7
2.4 课题来源及研究内容 7
2.4.1课题来源 7
2.4.2本课题研究内容 7
第三章 材料与方法 8
3.1 实验材料 8
3.1.1 菌株 8
3.1.2 实验试剂 8
3.1.3 实验仪器 8
3.1.4 培养基 9
3.2 实验方法 9
3.2.1 Ag@SL的制备条件优化 9
3.2.2 纳米银的表征 10
3.2.3 纳米银抗菌性能测定 10
第四章 结果与讨论 14
4.1 纳米银的制备条件优化 14
4.1.1反应时间的优化 14
4.1.2 反应温度的优化 15
4.1.3槐糖脂浓度的优化 15
4.1.4 反应体系pH的优化 16
4.2 纳米银基本表征 17
4.2.1纳米银SEM分析 17
4.2.2 Zeta电位值分析 17
4.3 抗菌性测试 18
4.3.1抑菌圈实验 18
4.3.2 抗菌成分的确定 19
4.3.3抗菌效果 21
第五章 结语与展望 24
5.1结语 24
5.2 展望 24
参考文献 25
致谢 27
第一章 引言
银纳米晶粒和一些单质金属纳米粒子已被证明有很多潜在的性能。具有明确的纳米结构特性的两种或更多种组分反应合成得到的复合材料,可以引入先进的化学、物理和生物特性[1-3]。然而,大多数报道的方法具有冗长复杂的实验步骤,到目前为止,用于实现这种结合物的方案依赖于传统的有机化学合成,设计和开发创新的方法来合成具有新颖功能的纳米银颗粒结构仍然有待探索[4,5]。
在众多的物理还原法,化学还原法和生物还原法中,以绿色化学为特点的生物还原法为制造功能性微纳米结构提供了一种环境友好的策略[6-8]。绿色合成途径具有节省能源、节约资源、高利用率、不使用有毒化学药品等环境友好的特点[9-12]。纳米颗粒的绿色合成可以使用细菌、酵母、真菌、植物材料和天然聚合物如明胶、壳聚糖、蛋白质和淀粉在细胞内或细胞外合成。近年来,使用天然生物质作为反应物或定向构建块来合成生物纳米材料是一个非常热门的话题[13-16]。已有使用植物提取的茶多酚(TP)[17]、Acacia(Ac)、Shikakai(Sh)和 Reetha(Rh)[18]等生物表面活性剂,以及 Trachyspermum ammi 和 Papaver somniferum[19]等植物的提取物,进行介导合成新型核壳结构银颗粒的相关研究。
相关图片展示: